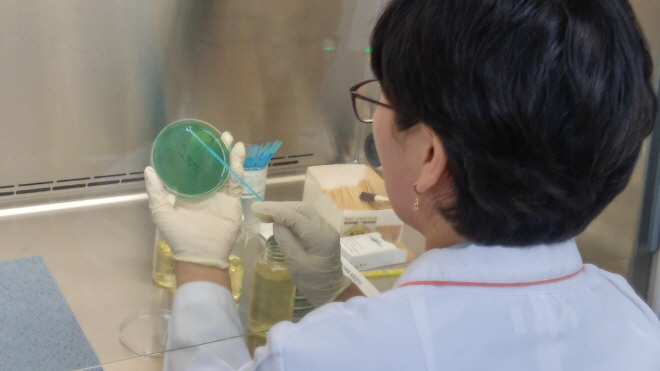

강진군, 여름철에도 안전한 먹거리만들기 추진
어패류취급업소 대상 수족관수 비브리오패혈증균 검사 시행
이정연 기자입력 : 2017. 08. 06(일) 15:43
[강진/시사종합신문]이정연 기자 = 강진군이 7월 한달간 시중 유통되는 해산물과 어패류 취급업소의 수족관수 등에 대하여 비브리오패혈증균 및 콜레라균 검사를 실시했다.
강진군의 주요 관광지인 마량놀토수산시장, 가우도 주변 횟집, 어판장 등을 비롯해 유통되는 생선류, 조개류 등의 비브리오패혈증균 검출이 우려되는 해산물과 어패류취급업소의 수족관에 대한 검사을 실시한 결과 비브리오패혈증균은 발견되지 않았다. 여름철 감염병을 일으키는 콜레라균에 대한 검사도 병행 실시한 결과 모두 정상으로 나타났다.
최근 들어 때이른 무더위로 해수의 온도가 24℃ 이상으로 높아졌다. 이에따라 군은 대군민 예방활동을 지속적으로 강화하고 반상회보, 군 홈페이지이 등 홍보매체를 활용해 대군민 홍보 활동을 지속적으로 전개해 나가고 있다. 비브리오패혈증은 비브리오 불니피쿠스균 감염에 의한 급성 패혈증으로써 간질환을 가지고 있는 환자에게서 주로 발생하는 감염병이다. 일반적으로 해수 온도가 18~20℃ 이상인 여름철에 주로 발생한다. 오염된 어패류를 생식하거나 상처가 난 피부가 오염된 바닷물에 접촉할 때 감염된다.
고 위험군에는 간질환자(만성간염·간경화·간암), 알콜중독자, 면역저하 환자 등이 해당된다. 사람 간 전파는 되지 않는다. 감염되었을 경우 20~48시간의 잠복기를 거쳐 복통, 급성발열, 오한, 구토, 설사 등의 증상이 동반된다. 발열 후 약 36시간 정도 경과되면 피부에 수포를 형성한 후 괴사성 병변으로 진행된다. 치사률이 약 50%에 이른다.
한편, 강진군보건소 송나윤소장은 비브리오패혈증 예방을 위해 “간질환이 있는 고위험군 환자는 어패류의 생식을 피하고, 여름철 어패류는 가급적 60℃ 이상으로 가열처리하는 것이 좋다. 또 -5℃ 이하로 저온 저장하거나 수돗물에 충분히 씻은 후 섭취하고 피부에 상처가 있을 때는 바닷물과 접촉을 피할 것”을 당부했다.
강진군의 주요 관광지인 마량놀토수산시장, 가우도 주변 횟집, 어판장 등을 비롯해 유통되는 생선류, 조개류 등의 비브리오패혈증균 검출이 우려되는 해산물과 어패류취급업소의 수족관에 대한 검사을 실시한 결과 비브리오패혈증균은 발견되지 않았다. 여름철 감염병을 일으키는 콜레라균에 대한 검사도 병행 실시한 결과 모두 정상으로 나타났다.
최근 들어 때이른 무더위로 해수의 온도가 24℃ 이상으로 높아졌다. 이에따라 군은 대군민 예방활동을 지속적으로 강화하고 반상회보, 군 홈페이지이 등 홍보매체를 활용해 대군민 홍보 활동을 지속적으로 전개해 나가고 있다. 비브리오패혈증은 비브리오 불니피쿠스균 감염에 의한 급성 패혈증으로써 간질환을 가지고 있는 환자에게서 주로 발생하는 감염병이다. 일반적으로 해수 온도가 18~20℃ 이상인 여름철에 주로 발생한다. 오염된 어패류를 생식하거나 상처가 난 피부가 오염된 바닷물에 접촉할 때 감염된다.
고 위험군에는 간질환자(만성간염·간경화·간암), 알콜중독자, 면역저하 환자 등이 해당된다. 사람 간 전파는 되지 않는다. 감염되었을 경우 20~48시간의 잠복기를 거쳐 복통, 급성발열, 오한, 구토, 설사 등의 증상이 동반된다. 발열 후 약 36시간 정도 경과되면 피부에 수포를 형성한 후 괴사성 병변으로 진행된다. 치사률이 약 50%에 이른다.
한편, 강진군보건소 송나윤소장은 비브리오패혈증 예방을 위해 “간질환이 있는 고위험군 환자는 어패류의 생식을 피하고, 여름철 어패류는 가급적 60℃ 이상으로 가열처리하는 것이 좋다. 또 -5℃ 이하로 저온 저장하거나 수돗물에 충분히 씻은 후 섭취하고 피부에 상처가 있을 때는 바닷물과 접촉을 피할 것”을 당부했다.


























